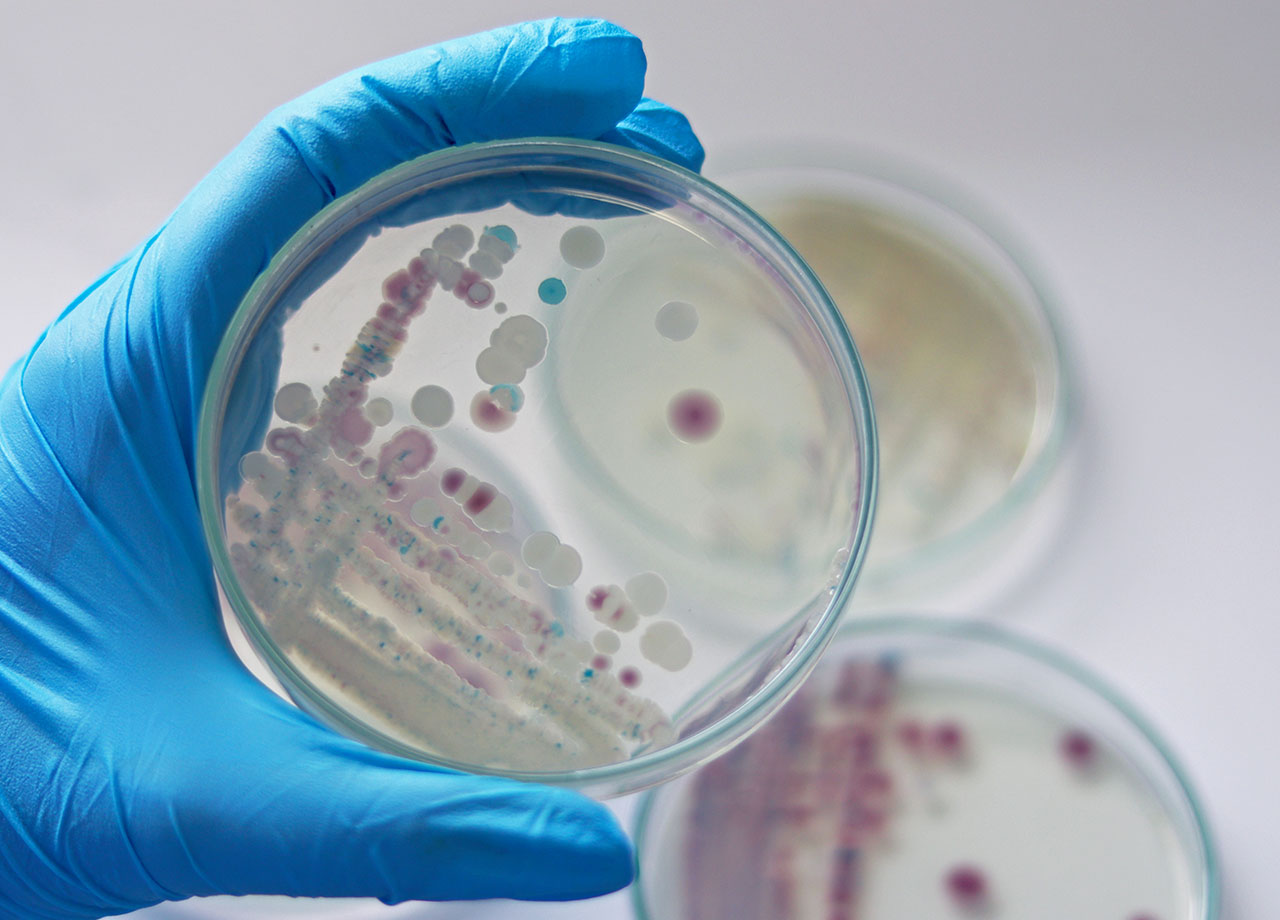

Oysters have shipped to restaurants and retailers in nine different states have been recalled after it was discovered they may be contaminated with Campylobacter jejuni, a bacteria that can cause diarrhea, nausea, and stomach cramps at best, and life-threatening illnesses at worst. Keep reading for more information about the recall.


Oyster Recall
According to both the Food and Drug Administration and the Department of Public Health, oysters harvested on July 1st and July 3rd from two different sites in Lewis Bay in Cape Cod have been linked to four cases of campylobacter illness, more commonly known as food poisoning. The shellfish dealers, Island Creek Oysters and Chatham Shellfish Co., voluntarily issued the recall on all oysters harvested between July 1st and July 18th. In addition, the state Division of Marine Fisheries closed the harvest area to being a growing area of investigation.
The oysters were distributed to restaurants and retailers in Massachusetts, California, Connecticut, Florida, Illinois, Minnesota, Missouri, New Jersey, New Hampshire, New York, and Pennsylvania, though the FDA noted that it's also possible that some of the potentially contaminated oysters made their way to other states as well.
Bacteria Contamination
The bacteria in question, called Campylobacter jejuni, is the most common cause of food poisoning, according to the Centers for Disease Control and Prevention. It's very difficult to detect, as the food could look, smell, and/or taste normal, but be contaminated with the bacteria anyways.
Symptoms include diarrhea (often bloody), high fever, stomach cramps, nausea, and vomiting. Symptoms may be more serious and even life-threatening for those with compromised immune symptoms. Individuals infected by the bacteria can unfortunately expect symptoms to last for two - seven days after consuming the contaminated food.

What You Should Do If You've Purchased A Recalled Product
So far, four individuals have developed food poisoning as a result of consuming the contaminated oysters. If you have consumed oysters recently at an establishment in one of the states where the oysters were distributed, monitor your symptoms, and if you're feeling ill, contact your health care provider for assistance.
If you've purchased oysters from a retail store in one of the affected states, check in with your local retailer to ensure that your oysters are not part of the recalled batch, and if they are, dispose of them immediately and do not consume.


























